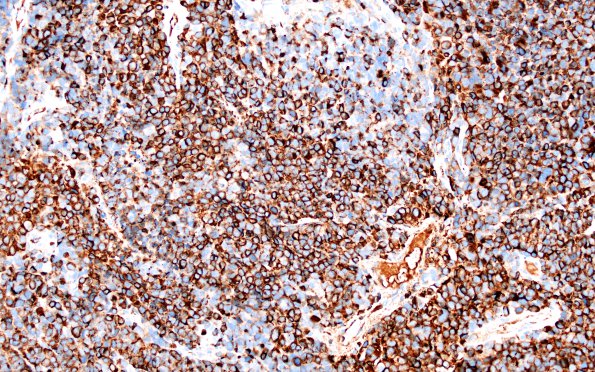
53C2 large cell neuroendocrine type (Case 53) CHR 1

Table of Contents
Washington University Experience | NEOPLASMS (METASTASES) | Microscopic | 53C2 large cell neuroendocrine type (Case 53) CHR 1
Tumor cells are strongly positive for chromogranin. ---- Not shown: TTF-1 labeled cells are very rare but present. The tumor is negative for p40, Melan-A, and S100. ---- The morphology and immunophenotype are most consistent with metastatic large cell neuroendocrine carcinoma, lung primary.